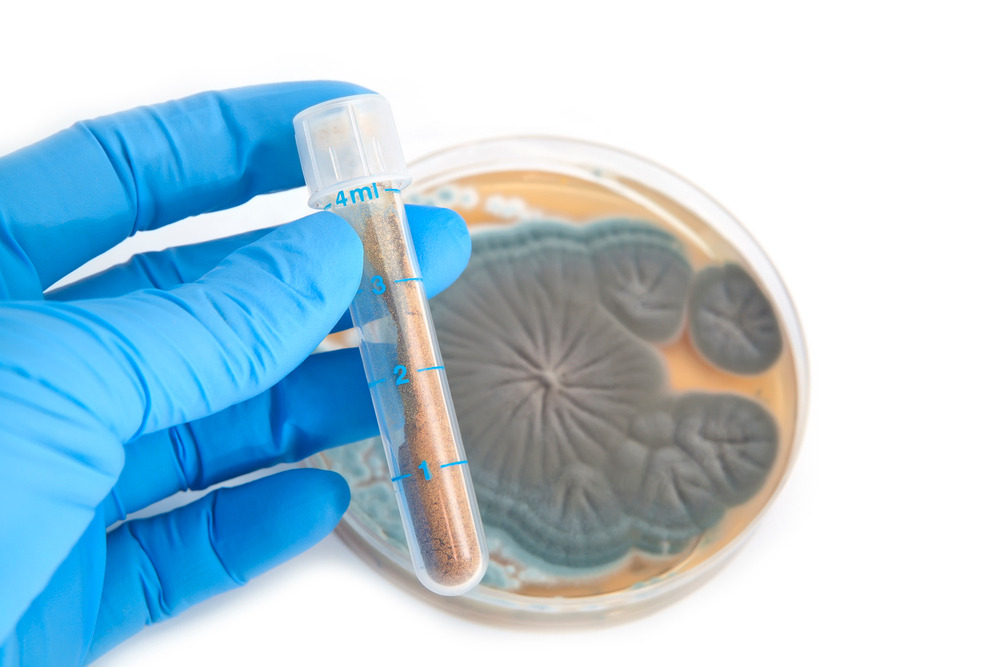
CK_yaytg041089_l.jpg

세상에 이렇게나 많은 항생제
by 볼빨간 약사
지난 시간에 항생제를 올바로 복용하는 방법에 대해 알아봤습니다. 이번 시간에는 심화학습으로 항생제에 대해 좀 더 공부하는 시간을 가져보도록 하겠습니다. 항생제의 작용 원리, 종류 등을 조금 깊이 있게 살펴볼 텐데 집중해주세요~ (항생제의 올바른 복용법은 아래 링크를 확인해주세요~)
# 비슷해 보이지만, 전혀 다른 항생제, 항바이러스제, 항진균제
항생제는 ‘미생물에 의해 만들어진 물질로 다른 미생물의 성장이나 생명을 막는 물질’을 말합니다. 처음 항생제의 발견은 미생물에서 유래한 천연물질이었습니다. 현재는 항생제 중에 합성된 것도 있고, 기존 항생제 구조 중 일부를 변경해 만든 반합성 물질도 있습니다. 이런 것들은 ‘항생제’ 보다는 ‘항균제’라는 표현이 정확하지만, 포괄적으로 이들 모두 ‘항생제’라 합니다. 여기서 구별해야 할 것으로 항바이러스제(바이러스를 억제하는 약제), 항진균제(진균, 즉 곰팡이균을 억제하는 약제)가 있습니다. 이들은 항생제나 항균제라고 부르지 않습니다. 항생제 및 항균제, 항바이러스제, 항진균제를 모두 포괄하는 용어로는 ‘항미생물제제(antimicrobial agents)’라는 표현도 있습니다. 여기서는 세균에 작용하는 약제인 ‘항생제’에 대해서 공부해보겠습니다.

# 기본 이 정도 스펙은 돼야 항생제라 할 수 있죠
항생작용을 하는 물질은 생물을 억제합니다. 그럼 세균뿐 아니라 인체 세포에도 해로울 수 있지 않을까?라는 생각이 들 수 있습니다. 아무리 좋은 항생제라도 세균 세포가 아닌 인체 세포까지 공격한다면 치료제로 사용할 수 없겠죠. 여기서 항생제들의 기본 특성이며 공통적인 작용원리인 ‘선택적 독성’을 주목할 필요가 있습니다. 항생제로 개발되기 위한 중요한 포인트는 세균 세포에만 선택적으로 작용해야 한다. 즉, 항생제가 작용하는 표적이 미생물의 성장 증식에는 필수적이면서 인체에는 없어야 합니다. 이처럼 항생제는 기본 특성으로 ‘선택적 독성’을 가집니다.

# 같이 항생제라 불리지만 종류는 천차만별
세부적인 작용 원리에 따라 여러 가지 종류로 분류가 가능합니다. 항생제의 분류는 항균 영역에 따라, 또는 작용기전에 따라 나눌 수 있습니다.
[항균 영역에 따른 항생제 분류]
먼저 항균 영역에 따라 분류해보겠습니다. 항균 영역이란 항생제가 어떤 종류의 세균에 효과적인지를 의미합니다. 보통 세균을 크게 분류하면 세균을 그람 염색이라는 방법으로 염색을 했을 때 염색되는 색깔에 따라 그람 음성균 또는 그람 양성균으로 분류합니다. 또, 모양에 따라 막대 모양의 막대균(=간균), 공 모양의 알균(=구균)으로 분류합니다. 이외에도 자라는 데 산소가 필요한지 유무에 따라서 호기성 세균, 혐기성 세균 등으로 분류하고 있습니다. 실제 임상에서는 그람 양성 알균과, 그람 음성 막대균이 흔합니다 그래서 항생제를 처방하는 의사들은 그람 양성균에 효과적인 항생제, 그람음성균에 효과적인 항생제, 혐기성 세균에 효과적인 항생제 등으로 구분해 항생제를 처방합니다.
[작용기전에 따른 항생제 분류]
다음으로 작용기전에 따라서 분류할 수 있습니다. 세균을 저해하는 원리에 따라 1)세균 세포벽 합성 저해 항생제 2) 세균 세포막 기능 저해 항생제 3) 세균 증식 저해 항생제로 구분합니다. 이 중, 3)세균 증식 저해 항생제는 좀 더 세부적으로 3-1)엽산 합성 저해 항생제, 3-2)핵산 합성 저해 항생제, 3-3)단백질 합성 저해 항생제로 나뉩니다.
<항생제의 작용 기전에 의한 분류>
+ 세포벽 합성 억제 : 베타 람탁계 항생제, 반코마이신 등
+ 세포막 투과의 변화 : 암포테리신, 폴리믹신 등
+ 단백합성 억제 : 테트라사이클린, 아미노글리코사이드, 마크로라이드 등
+ 핵산합성 억제 : 리팜핀, 퀴놀론
+ 엽산합성 억제 : 설파계, 피리메타민
1) 세균 세포벽 합성 저해 항생제
세균의 세포는 인체 세포에는 없는 ‘세포벽’이란 구조로 둘러싸여 있습니다. 그래서 인체 내의 삼투압보다 훨씬 높은 세균 내 압력을 유지하며 살아갑니다. 튼튼한 세포벽 때문에 터지지 않고 유지가 되는 것이죠. 세포벽의 합성을 저해하는 항생제는 결국 세균의 세포벽이 제대로 만들어지지 못하게 함으로써 세균 세포가 파괴되도록 하여 세균을 죽입니다.
세균의 세포벽 합성을 억제하는 항생제에는 화학구조적으로 베타락탐(β-lactam) 고리 구조를 가지고 있는 베타락탐계 항생제(‘페니실린(penicillin)계 항생제’와 ‘세팔로스포린(cephalosporin)계 항생제’)와 반코마이신 같은 항생제가 대표적입니다. ‘페니실린계 항생제’는 광범위하게 세균을 죽일 수 있으며 아목시실린이 대표적입니다. ‘세팔로스포린계 항생제’는 항균 범위(억제할 수 있는 균의 범위)에 따라서 1~4세대로 나뉩니다. 하지만 세대가 높다고 항균 범위가 넓어지고 강력해지는 것은 아닙니다. 대표적인 것으로 세파클러, 세파드록실, 세파드린, 세팔렉신, 세픽심, 세포탁심 등이 있습니다.
세균 중에는 세포벽이 없는 마이코플라즈마(Mycoplasma) 등과 같은 세균도 있습니다. 이런 세균에는 세포벽 합성을 저해하는 항생제를 투여해도 작용할 세포벽이 없기 때문에 항균효과를 볼 수 없습니다. 마찬가지로 사람의 세포에도 작용할 세포벽이 없기 때문에 항생제를 복용해도 영향을 미치지 않습니다.
2) 세균 세포막 기능 저해 항생제 (세포막 투과성의 변화)
세균의 세포막 기능을 저해하는 항생제도 있습니다. 세포막의 투과성을 변화시켜 세균의 세포가 균형을 잃게 해 죽게 하는 원리입니다. 세포를 둘러싸고 있는 세포막은 선택적 능동 수송을 함으로써 세포 안의 구성물질을 조절하는데, 세포막의 투과성이 변화되면서 세포 내에 있어야 할 중요 물질들이 세포 밖으로 빠져나와 세포가 죽게 됩니다. 세균의 세포막은 사람의 세포막과 다르기 때문에 세균에만 선택적으로 작용할 수 있으며 대표적으로 ‘폴리믹신(Polymyxin)’이 있습니다.
3) 세균 증식 저해 항생제
세균이 증식하기 위해서는, 쉽게 말하면 세균의 세포가 분열을 하기 위해서는 세포 내에서 DNA와 RNA라는 유전물질이 만들어지고, 이로부터 단백질이 합성되는 과정이 필요합니다. 그런데 이 단계 중 어딘가를 저해하게 되면 세균의 증식이 억제됩니다.
여기에서 어느 단계를 막느냐에 따라서 3-1) 엽산 합성 저해 항생제, 3-2) 핵산 합성 저해 항생제, 3-3) 단백질 합성 저해 항생제, 로 구분할 수 있습니다.
3-1) 엽산 합성 저해 항생제
유전물질인 핵산(우리가 DNA, RNA라고 알고 있는 것들) 합성의 중요한 전구물질 ‘엽산’의 합성을 억제하는 약물이 항생제로 이용되고 있습니다. 사람은 엽산이 몸에서 만들어지지 않아 음식을 통해 외부에서 섭취해야 하는데, 세균은 외부의 엽산을 이용할 능력이 없고 몸안에서 자체적으로 엽산을 만들어 사용합니다. 따라서 엽산 합성과정을 방해하는 약물은 사람의 세포에는 영향을 주지 않지만 세균에게는 지장을 주어 항균력을 보이게 됩니다. 대표적으로 ‘술폰아미드(Sulfonamide)계열 항생제’가 있습니다.
3-2) 핵산 합성 저해 항생제
유전물질인 핵산 합성을 억제하는 항생제는 DNA의 전사 및 RNA 형성을 방해하여 항균작용을 나타냅니다. 대표적으로 ‘퀴놀론(quinolone)계 항생제’와 ‘리팜피신(rifampicin)’이 있습니다. ‘퀴놀론계 항생제’는 DNA에 작용하고, ‘리팜피신’은 RNA에 작용하여 모두 항균작용을 합니다.
3-3) 단백질 합성 저해 항생제
세균이 증식하려면 필요한 단백질이 세포질 내에서 합성돼야 합니다. 단백질 합성은 ‘리보솜’이란 세포 내 소기관에서 이루어집니다. 단백질 합성 저해 항생제는 세균의 리보솜에 선택적으로 작용해 세균의 단백질 합성을 저해함으로써 항균작용을 합니다. 대표적으로 ‘아미노글리코사이드(aminoglycoside) 계열’의 겐타마이신, ‘마크로라이드(macrolide) 계열’의 에리스로마이신, 아지트로마이신, 클래리트로마이신, ‘테트라사이클린(tetracycline) 계열’의 독시사이클린, 미노사이클린 등이 있습니다.
여기서 사람 세포의 리보솜과 세균의 리보솜은 그 구조가 다르기 때문에 이 항생제를 먹어도 사람의 세포는 상기 항생제의 영향을 적게 받게 됩니다.
<대표적인 항생제의 종류>

1. NAVER 지식백과 약학용어사전 내 ‘항생제’
2. 질병관리청 국가건강정보포털 > 건강정보 > 건강정보 ㄱ~ㅎ. > 항생제. https://health.kdca.go.kr/healthinfo/biz/health/gnrlzHealthInfo/gnrlzHealthInfo/gnrlzHealthInfoView.do (as of 2022-06-10)